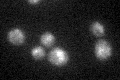
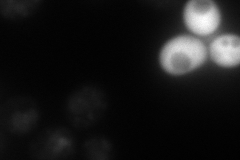
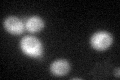
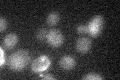

View description
Peptidyl-prolyl cis-trans isomerase (cyclophilin), catalyzes the cis-trans isomerization of peptide bonds N-terminal to proline residues; similarity to Cpr4p suggests a potential role in the secretory pathway
Localization:
Intensity:
Fold change:
Significance:
-
C’ GFP library in SD
vacuole23.78 -
N' NOP1pr-GFP in SD
punctate,vacuole membrane61.1747 -
N' TEF2pr-mCherry in SD

missing0 -
N' NATIVEpr-GFP in SD

missing0 -
N' TEF2pr-VC and Cyto-VN in SD

#N/A0 -
C’ GFP library in SD+DTT
vacuole20.60.86No -
C’ GFP library in SD+H2O2

vacuole21.580.9No -
C’ GFP library in Starvation Media
vacuole20.220.85No -
C’ GFP library on the background of Pup2-DaMP

vacuole -
C’ GFP library on the background of CCT mutant

vacuole20.07430.84372No
